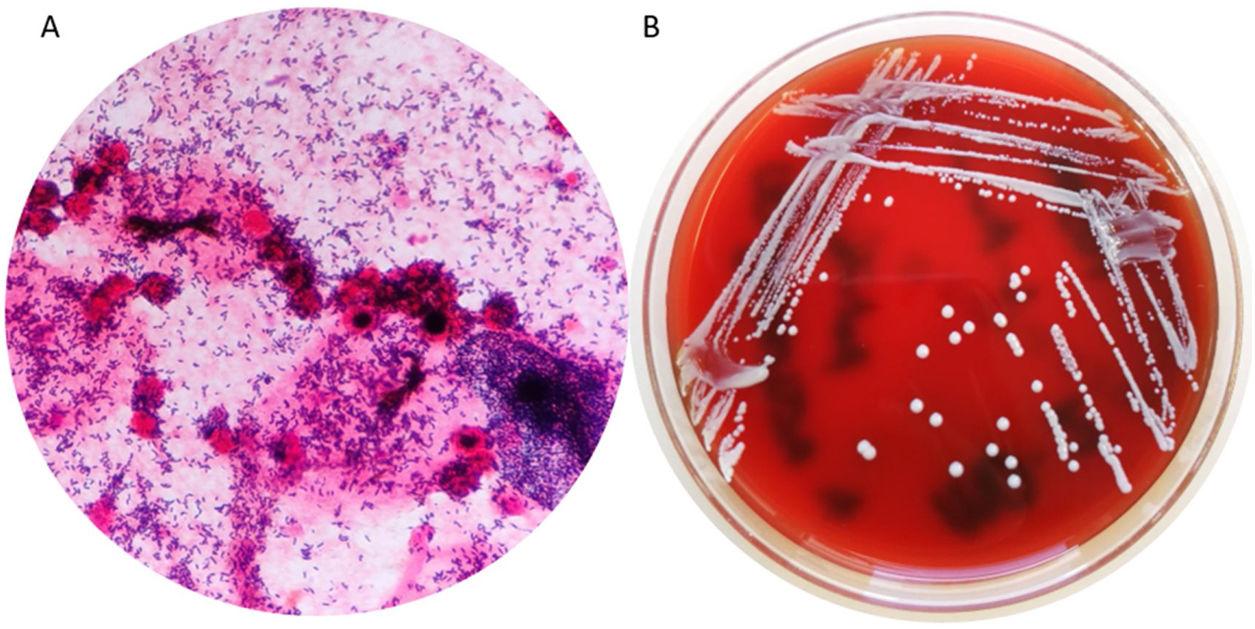
Actinomyces Colony Morphology

Actinomyces Urease Positive
Immerse yourself in the artistic beauty of Actinomyces Urease Positive through extensive collections of inspiring images. where technical excellence meets creative vision and artistic expression. transforming ordinary subjects into extraordinary visual experiences. Each Actinomyces Urease Positive image is carefully selected for superior visual impact and professional quality. Ideal for artistic projects, creative designs, digital art, and innovative visual expressions All Actinomyces Urease Positive images are available in high resolution with professional-grade quality, optimized for both digital and print applications, and include comprehensive metadata for easy organization and usage. Our Actinomyces Urease Positive collection inspires creativity through unique compositions and artistic perspectives. Whether for commercial projects or personal use, our Actinomyces Urease Positive collection delivers consistent excellence. Advanced search capabilities make finding the perfect Actinomyces Urease Positive image effortless and efficient. Multiple resolution options ensure optimal performance across different platforms and applications. The Actinomyces Urease Positive archive serves professionals, educators, and creatives across diverse industries. Diverse style options within the Actinomyces Urease Positive collection suit various aesthetic preferences. The Actinomyces Urease Positive collection represents years of careful curation and professional standards. Instant download capabilities enable immediate access to chosen Actinomyces Urease Positive images. Our Actinomyces Urease Positive database continuously expands with fresh, relevant content from skilled photographers.